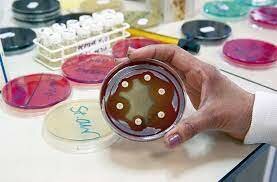
Golden Age Part Two

-
 The first synthetic antibiotic used clinically. Salvarsan was discovered and used as a treatment for syphilis.
The first synthetic antibiotic used clinically. Salvarsan was discovered and used as a treatment for syphilis. -
 Alexander Fleming discovered Penicillin in a petri dish by accident.
Alexander Fleming discovered Penicillin in a petri dish by accident. -
 Prontosil was introduced in the 1930s and was refined many times later on. Prontosil was discovered and created by German chemist and pathologist Gerhard Domagk. Prontosil prevented mortality in mice infected with Streptococcus bacteria.
Prontosil was introduced in the 1930s and was refined many times later on. Prontosil was discovered and created by German chemist and pathologist Gerhard Domagk. Prontosil prevented mortality in mice infected with Streptococcus bacteria. -
 Penicillin passes many clinical trials and is on its way to becoming an antibiotic.
Penicillin passes many clinical trials and is on its way to becoming an antibiotic. -
 Penicillin becomes an antibiotic and starts being mass-produced.
Penicillin becomes an antibiotic and starts being mass-produced. -
 Cephalosporin was discovered by Italian scientist Giuseppe Brotzu. He discovered that cephalosporin produced substances that were effective against Salmonella typhi, the cause of typhoid fever, which had β-lactamase.
Cephalosporin was discovered by Italian scientist Giuseppe Brotzu. He discovered that cephalosporin produced substances that were effective against Salmonella typhi, the cause of typhoid fever, which had β-lactamase. -
 Penicillin pushed other microbiologists and physicians to start finding more antibiotics. This causes the golden age for antibiotics.
Penicillin pushed other microbiologists and physicians to start finding more antibiotics. This causes the golden age for antibiotics. -
There were so many antibiotics discovered, there was practically one every year. Some of the antibiotics discovered in the 50s include Oxytetracycline, Procaine benzylpenicillin, Erythromycin, Benzathine benzylpenicillin, and many more.
There were so many antibiotics discovered, there was practically one every year. Some of the antibiotics discovered in the 50s include Oxytetracycline, Procaine benzylpenicillin, Erythromycin, Benzathine benzylpenicillin, and many more. -
 The golden age of antibiotics peaked around 1960 and has slowly declined ever since. There were so many antibiotics discovered that over half of the antibiotics used today were discovered in the 1950s.
The golden age of antibiotics peaked around 1960 and has slowly declined ever since. There were so many antibiotics discovered that over half of the antibiotics used today were discovered in the 1950s. -
 After the Golden age, most antibiotics were in the process of being refined. For example, Carbenicillin, Pivampicillin, Amoxicillin, and many more types of antibiotics were created.
After the Golden age, most antibiotics were in the process of being refined. For example, Carbenicillin, Pivampicillin, Amoxicillin, and many more types of antibiotics were created. -
 Cubicin is the most recently discovered antibiotic. It's used by injection to treat vancomycin-resistant S. aureus (VRSA) and was discovered in Streptomyces roseosporus in 1987.
Cubicin is the most recently discovered antibiotic. It's used by injection to treat vancomycin-resistant S. aureus (VRSA) and was discovered in Streptomyces roseosporus in 1987. -
 After 1987, there have been zero antibiotic discoveries to this day.
After 1987, there have been zero antibiotic discoveries to this day.
